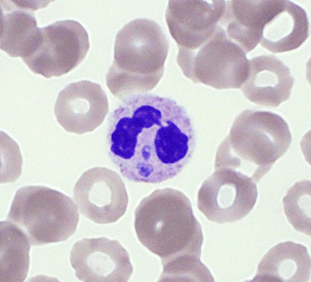
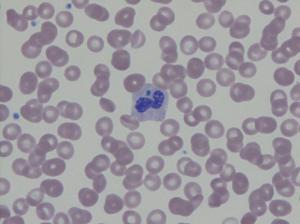
Blood smear showing granulocyte with intracytoplasmic morulae.

An 83 year old man presents to an emergency department after an unwitnessed fall and being found down for an undetermined amount of time. His past medical history includes dementia and type II diabetes mellitus. A tick is found in his left groin. Workup reveals mild rhabdomyolysis, mild transaminitis, thrombocytopenia, and multiple infiltrates on chest x-ray, concerning for aspiration pneumonia. His hospital course is complicated by fever, hypotension, and atrial fibrillation with rapid ventricular response. Representative images from his peripheral blood smear are shown below.

PCR confirmed the diagnosis of Anaplasma phagocytophilum. The patient recovered after a 10-day course of doxycycline.
Differentiating Tick-Borne Intracellular Microorganisms
The clinical findings of recent tick exposure, thrombocytopenia, transaminitis, and acute illness are consistent with acute infection with either Ehrlichia or anaplasma. The images depict morulae (microcolonies of bacteria) within the cytoplasm of neutrophils. A. phagocytophilum, Ehrlichia chaffeensis, and Babesia microti can all be seen intracellularly on peripheral blood smears. A. phagocytophilum preferentially infects neutrophils, while E. chaffeensis infects monocytes and B. microti infects erythrocytes. Unlike A. phagocytophilum and E. chaffeensis, which both appear as intracellular morulae (clusters of bacteria), B. microti is a protozoa whose trophozoite forms are seen in red blood cells as delicate rings or grouped in tetrads (the characteristic “Maltese cross”).
The finding of morulae in granulocytes has a sensitivity of 20-80% for anaplasmosis within the first week of infection. However, morulae within granulocytes are also found in infection with Ehrlichia ewingii (human granulocytotropic Ehrlichiosis, distinct from human monocytotropic Ehrlichiosis caused by E. chaffeensis), a less common relative of E. chaffeensis that is also transmitted by the Lone Star tick (Amblyomma americanum) and appears to preferentially infect immunocompromised hosts. For E. chaffeensis, the sensitivity of finding morulae in monocytes is only 7-17% amongst immunocompetent hosts.
References
- Chapman, AS, JS Bakken, SM Folk, et al. “Diagnosis and management of tickborne rickettsial diseases: Rocky Mountain spotted fever, ehrlichioses, and anaplasmosis–United States: a practical guide for physicians and other health-care and public health professionals.” MMWR Recomm. Rep. 2006; 55(RR-4):1.
- McPherson, R, and M Pincus. (2011). Henry’s Clinical Diagnosis and Management By Laboratory Methods (22nd Edition, pp. 1073-1074, 1205). Philadelphia, PA: Elsevier Saunders.
- Paddock, CD, SM Folk, GM Shore, et al. “Infections with Ehrlichia chaffeensis and Ehrlichia ewingii in persons coinfected with human immunodeficiency virus.” Clin Infect Dis. 2001; 33(9):1586-94.
- Schotthoefer, AM, JK Meece, LC Ivacic, et al. “Comparison of a Real-Time PCR Method with Serology and Blood Smear Analysis for Diagnosis of Human Anaplasmosis: Importance of Infection Time Course for Optimal Test Utilization.” J Clin Microbiol. 2013 Jul; 51(7): 2147-2153.
-Frederick Eyerer, MD is a 3rd year anatomic and clinical pathology resident at the University of Vermont Medical Center.

-Christi Wojewoda, MD, is the Director of Clinical Microbiology at the University of Vermont Medical Center and an Associate Professor at the University of Vermont.